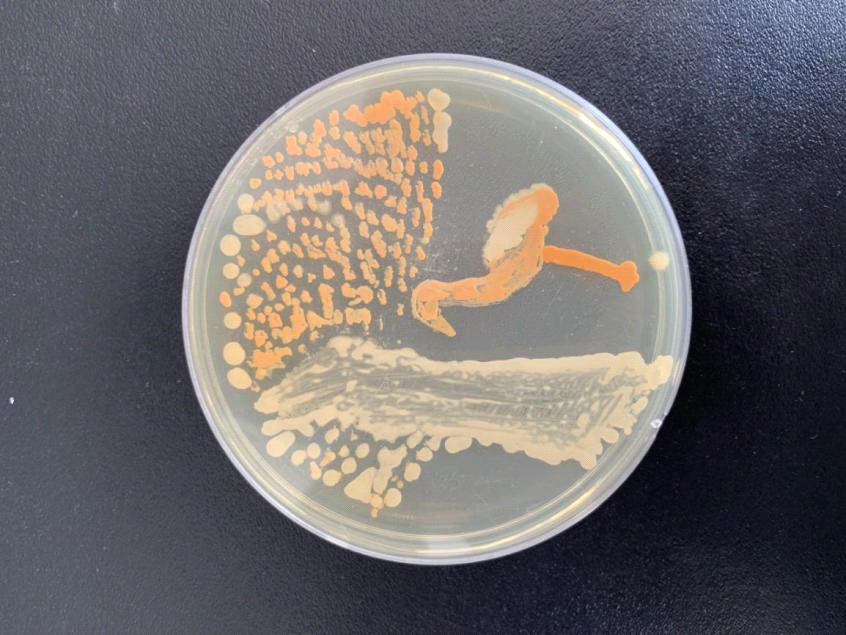

Jilin students create paintings with bacteria on petri dishes
Share - WeChat

- Academician Ji Xunming named president and deputy Party secretary
- 19 punished for role in medical admission case
- US' whitewashing of Japan's aggression and war crimes criticized
- ILO China conducts training on post-earthquake recovery in Myanmar
- China's State Council appoints, removes officials
- Exhibition on CPC's crucial role in war against Japanese aggression opens